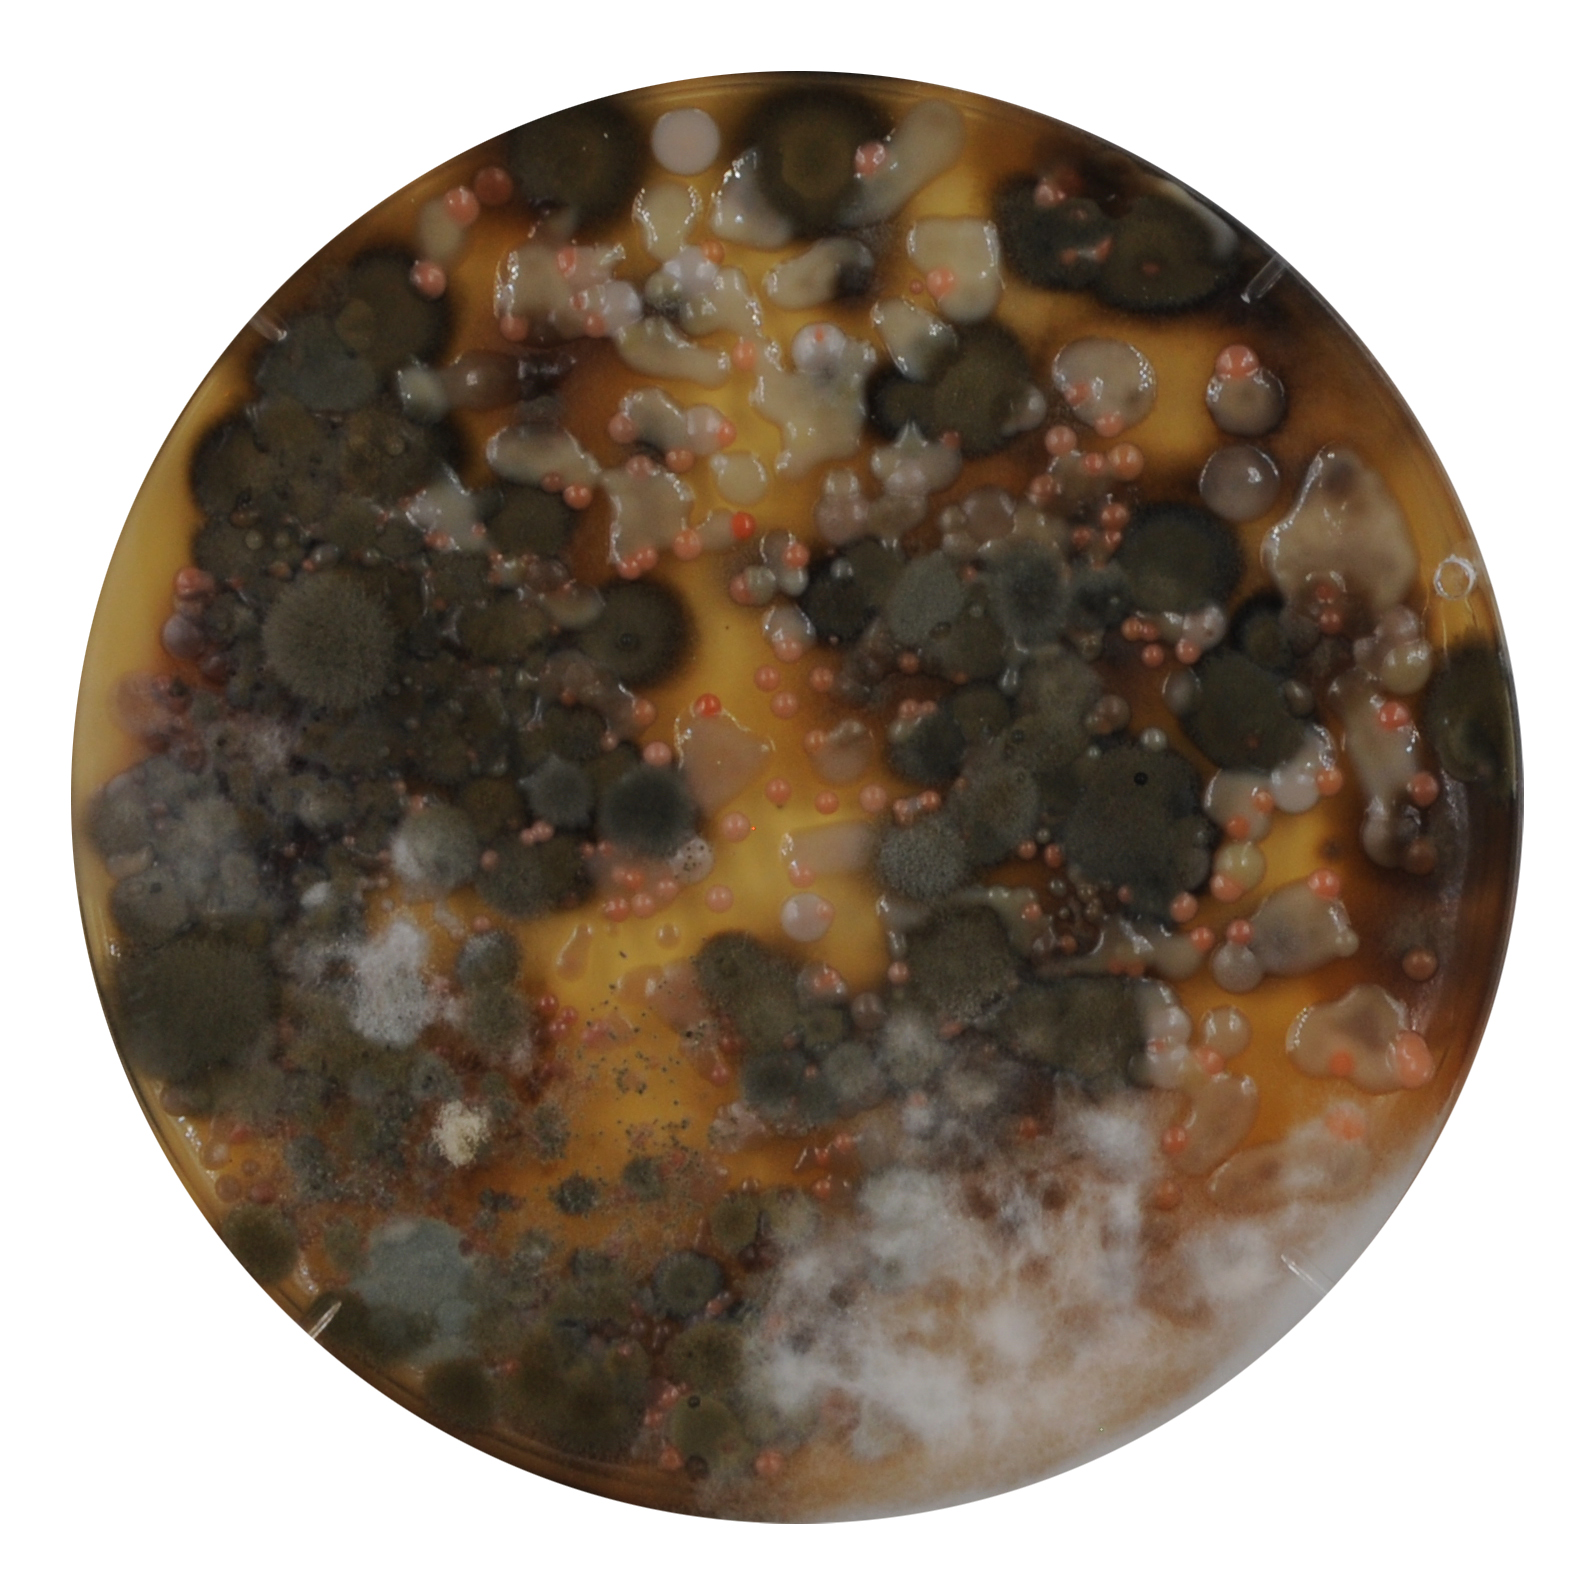
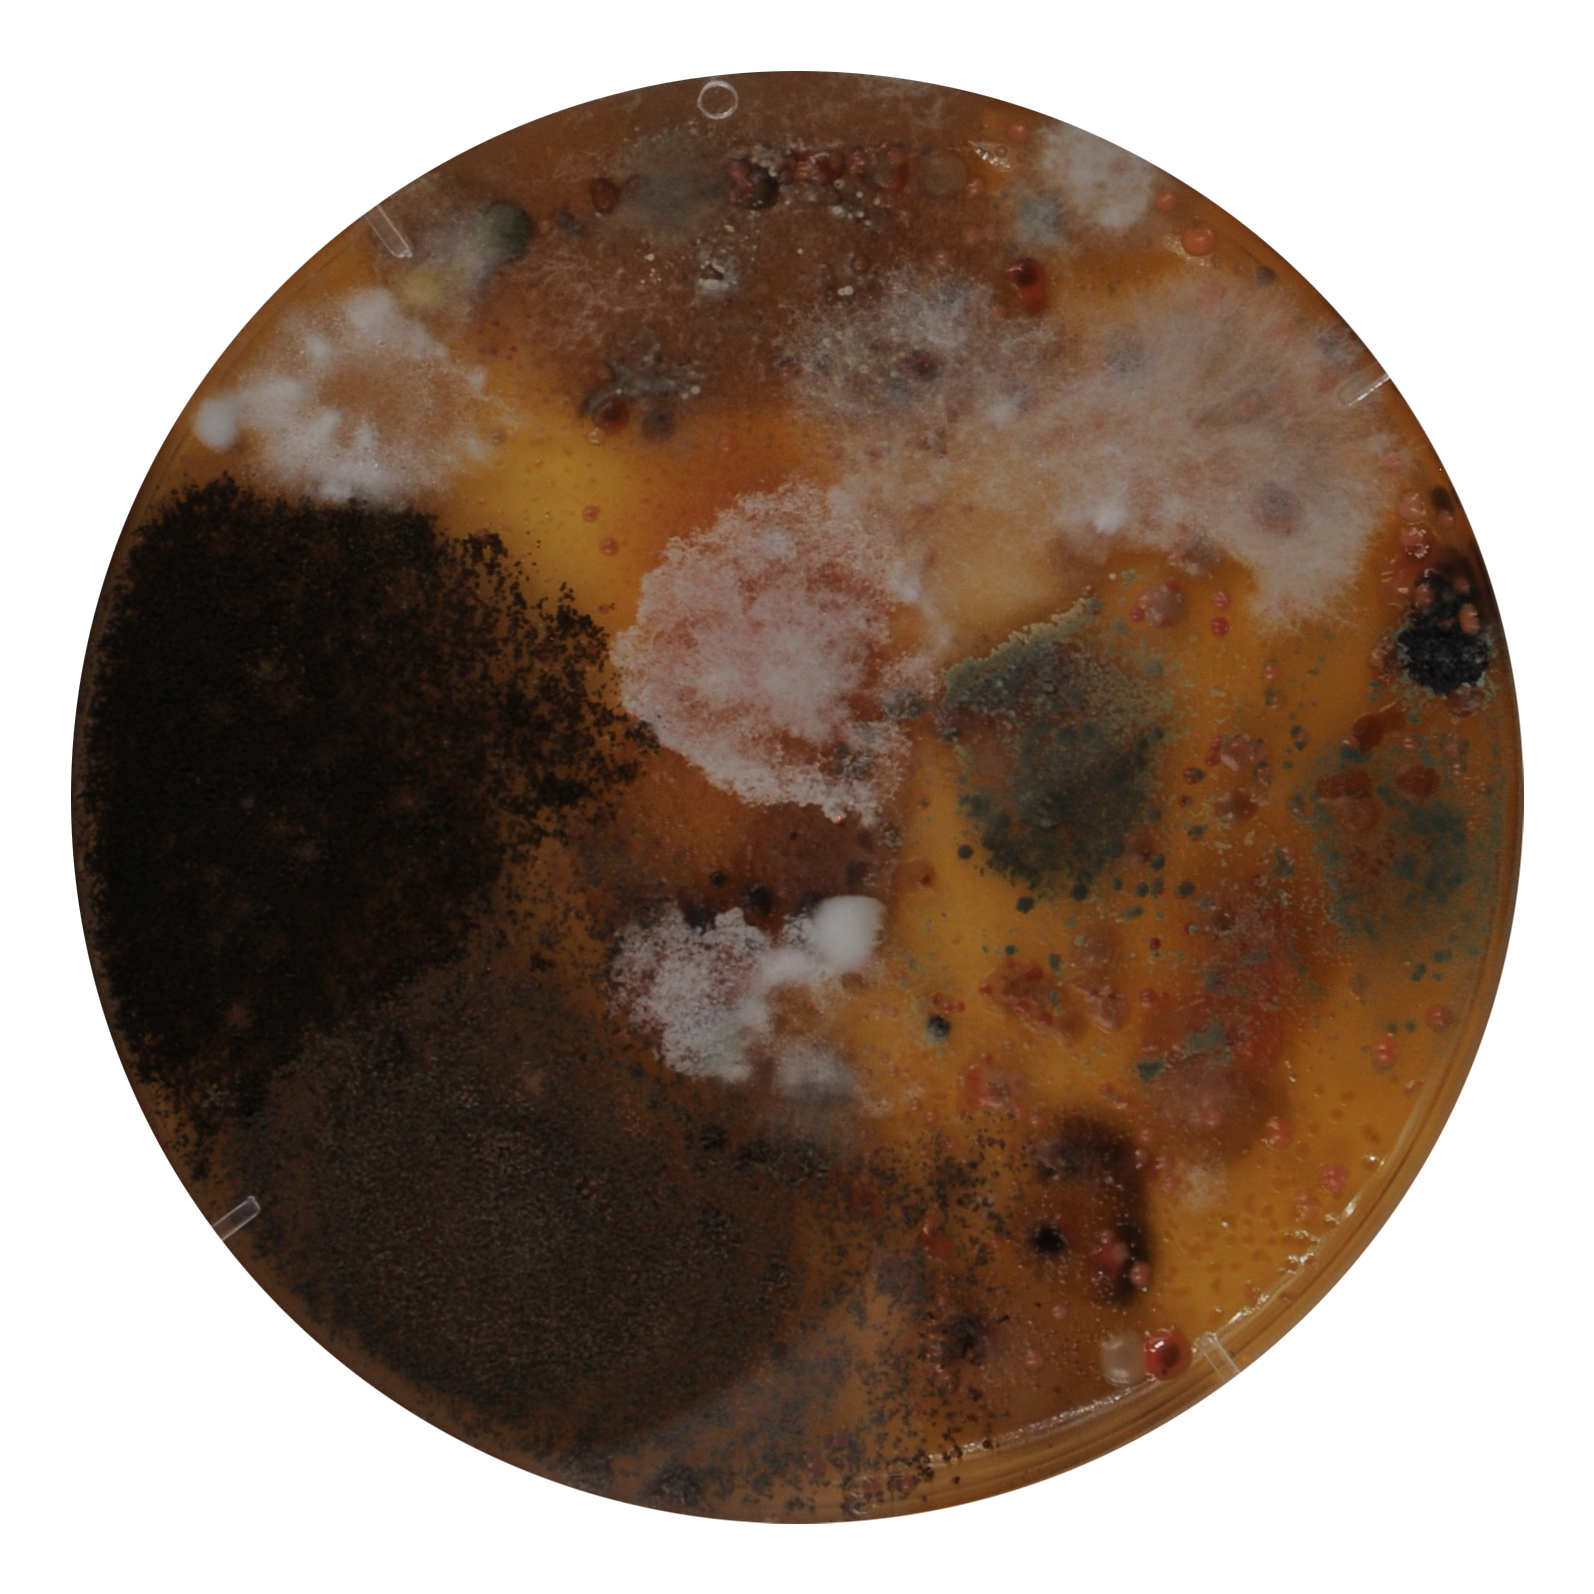
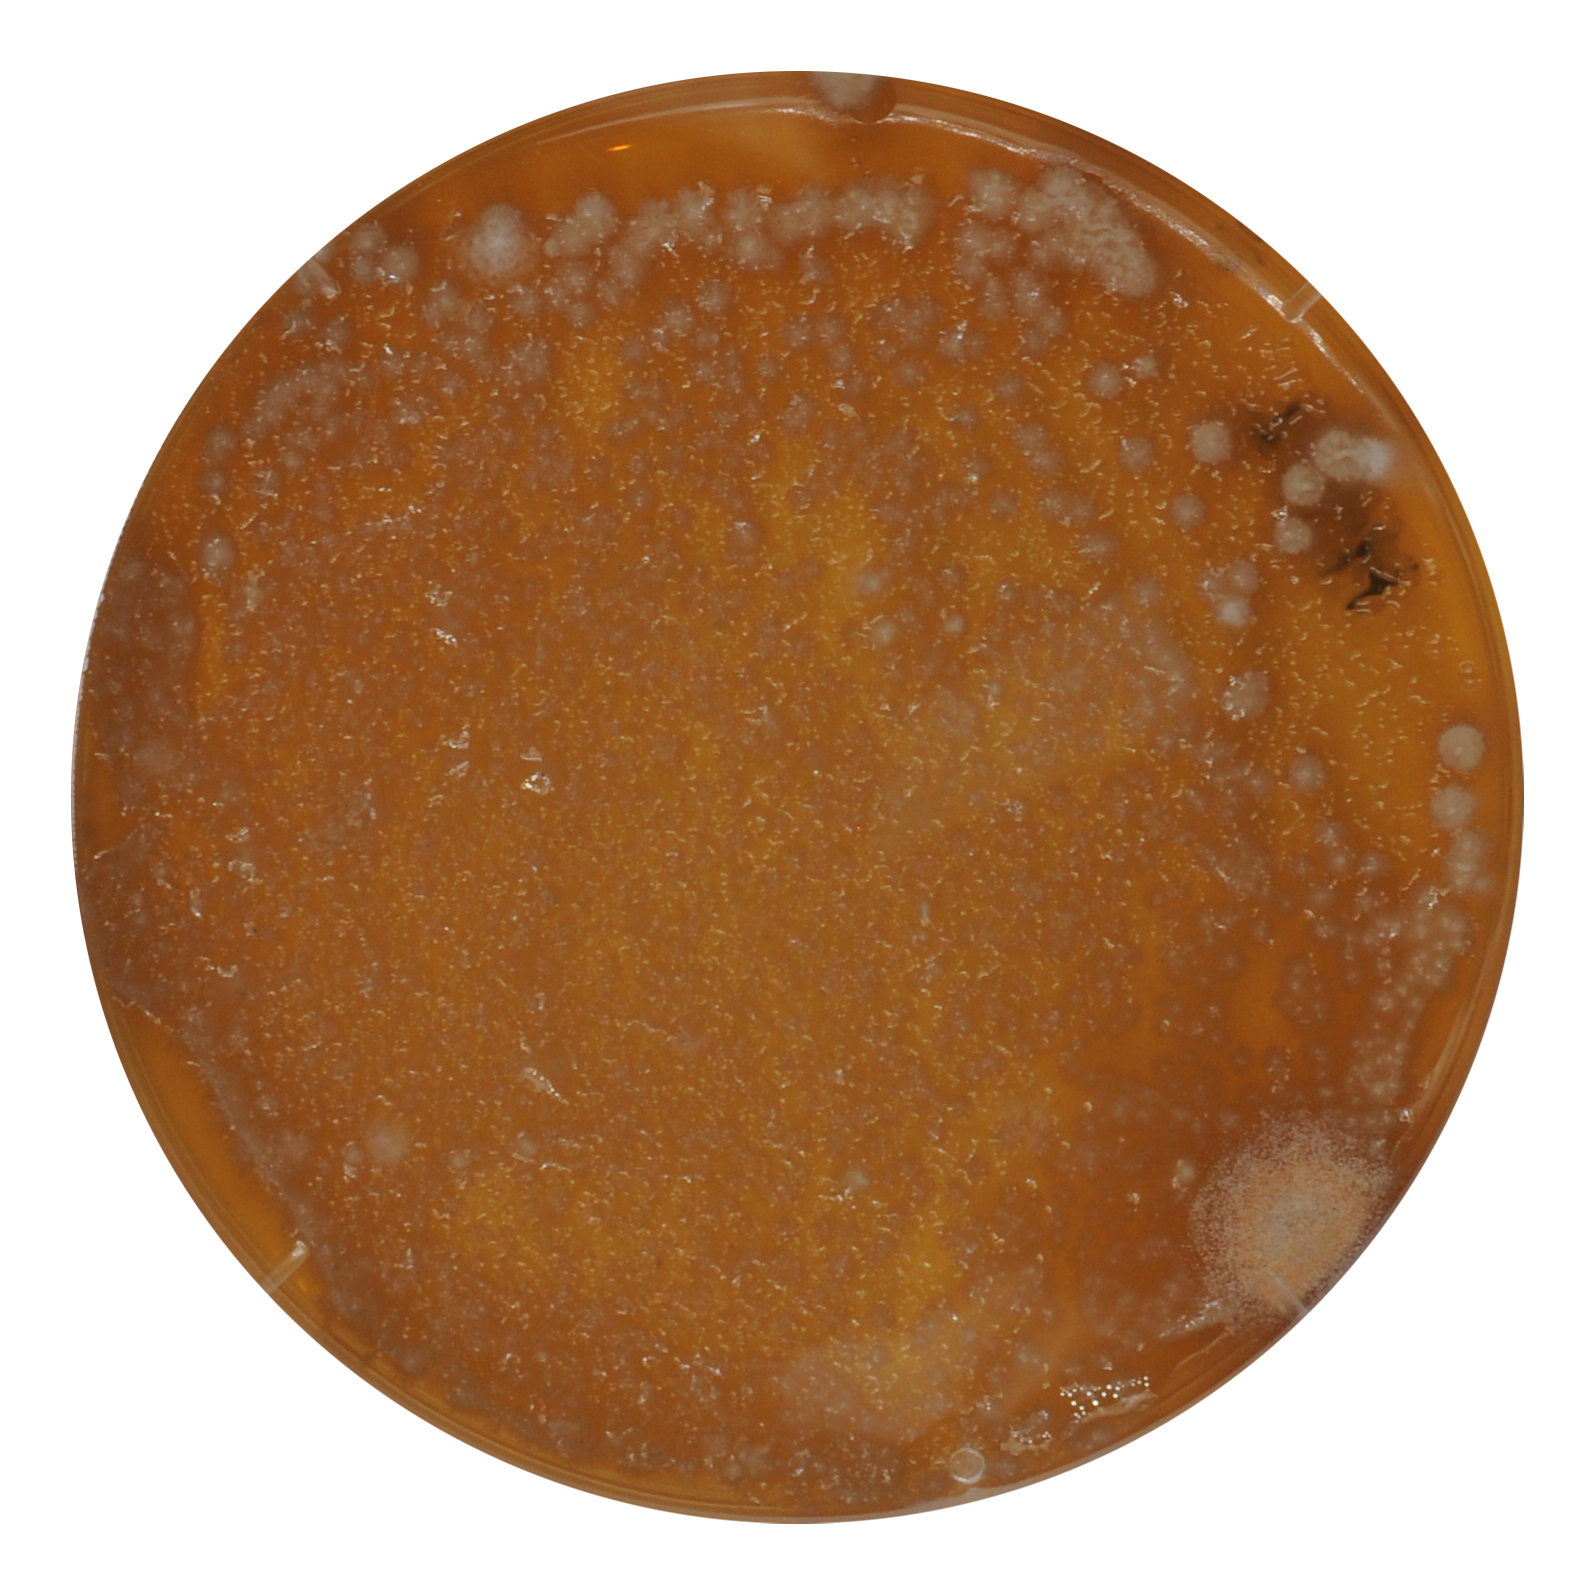
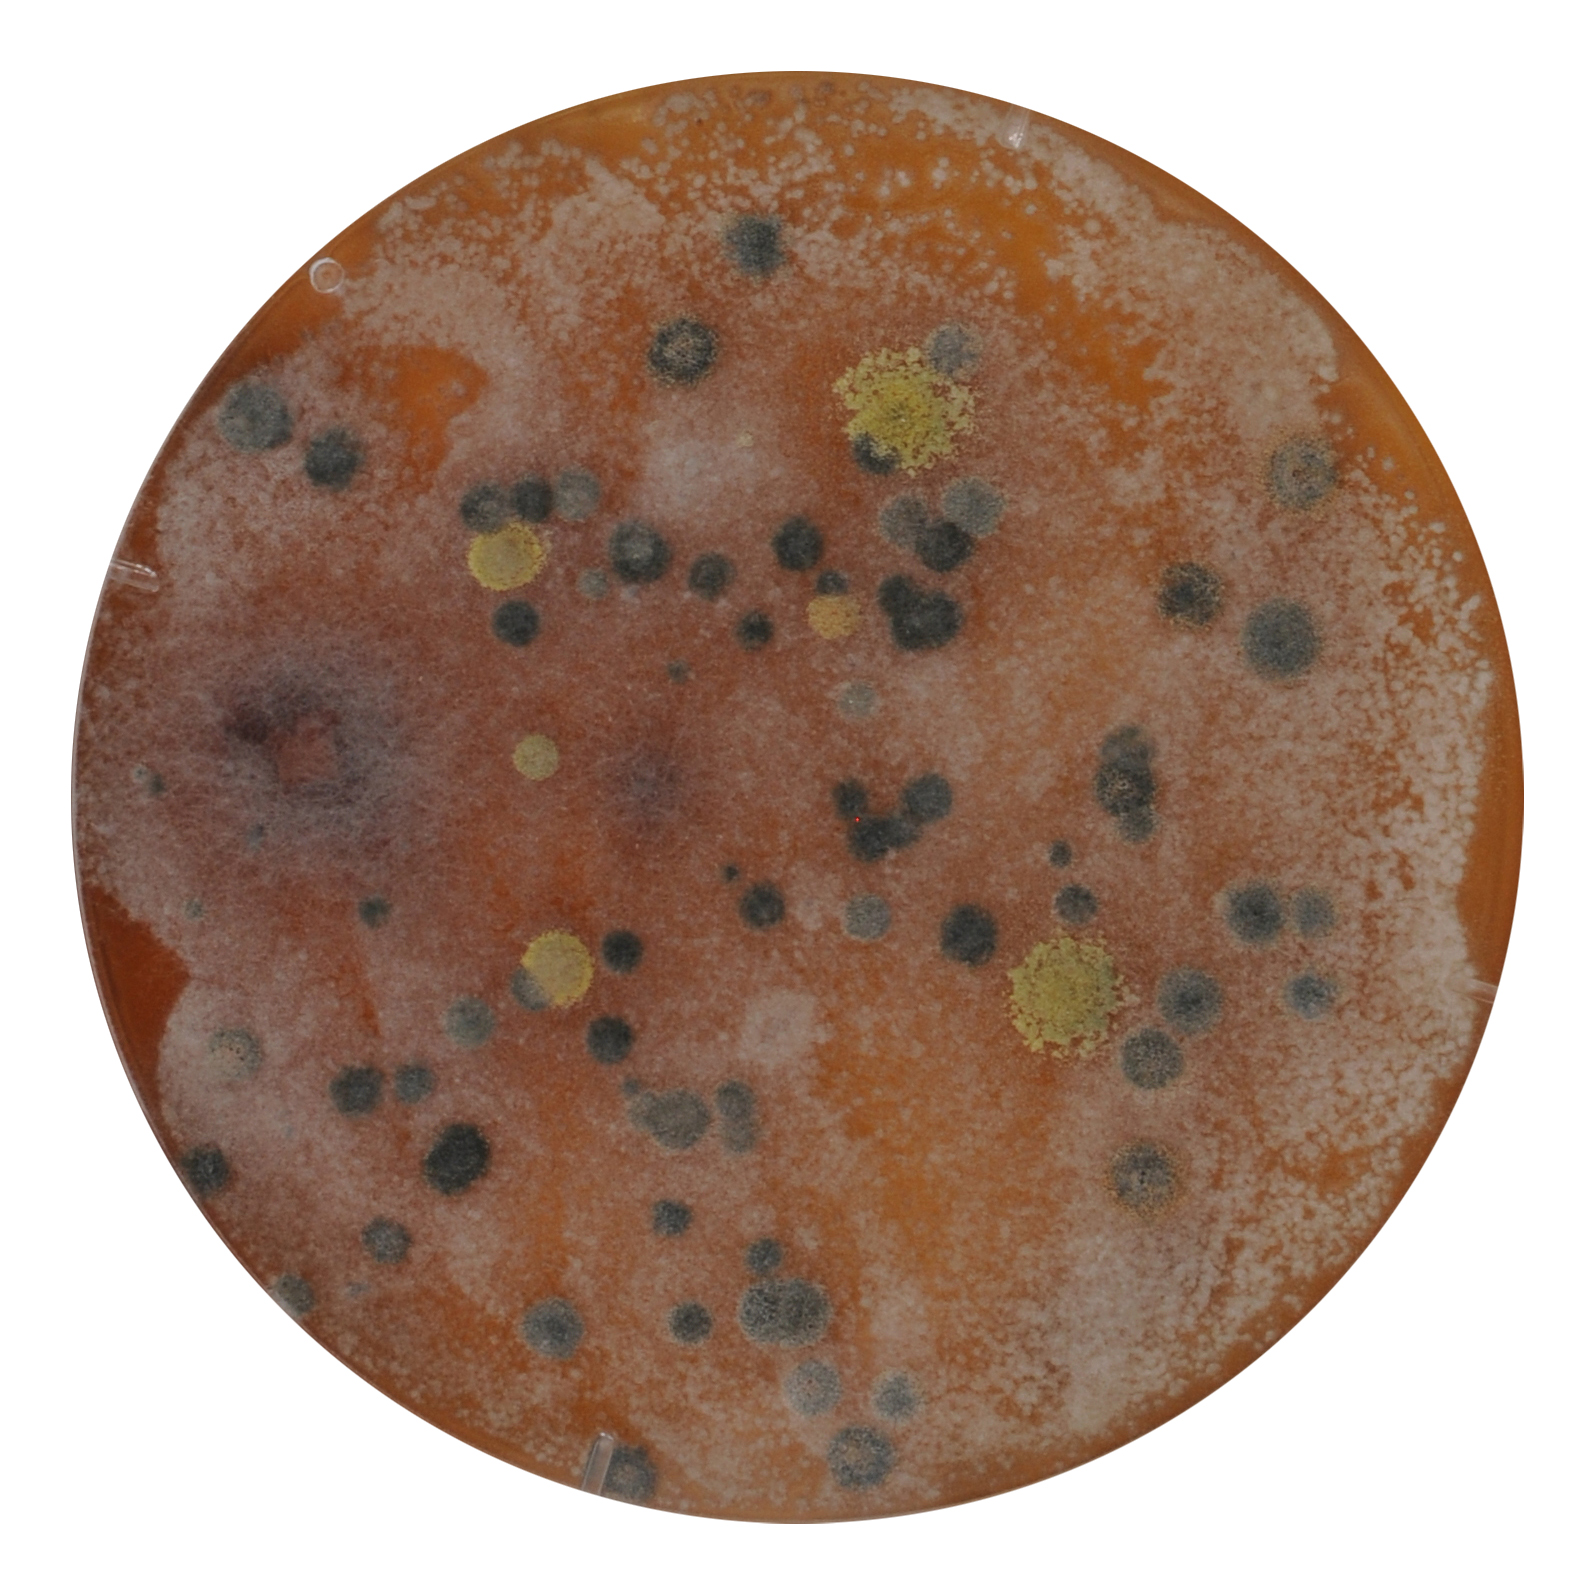
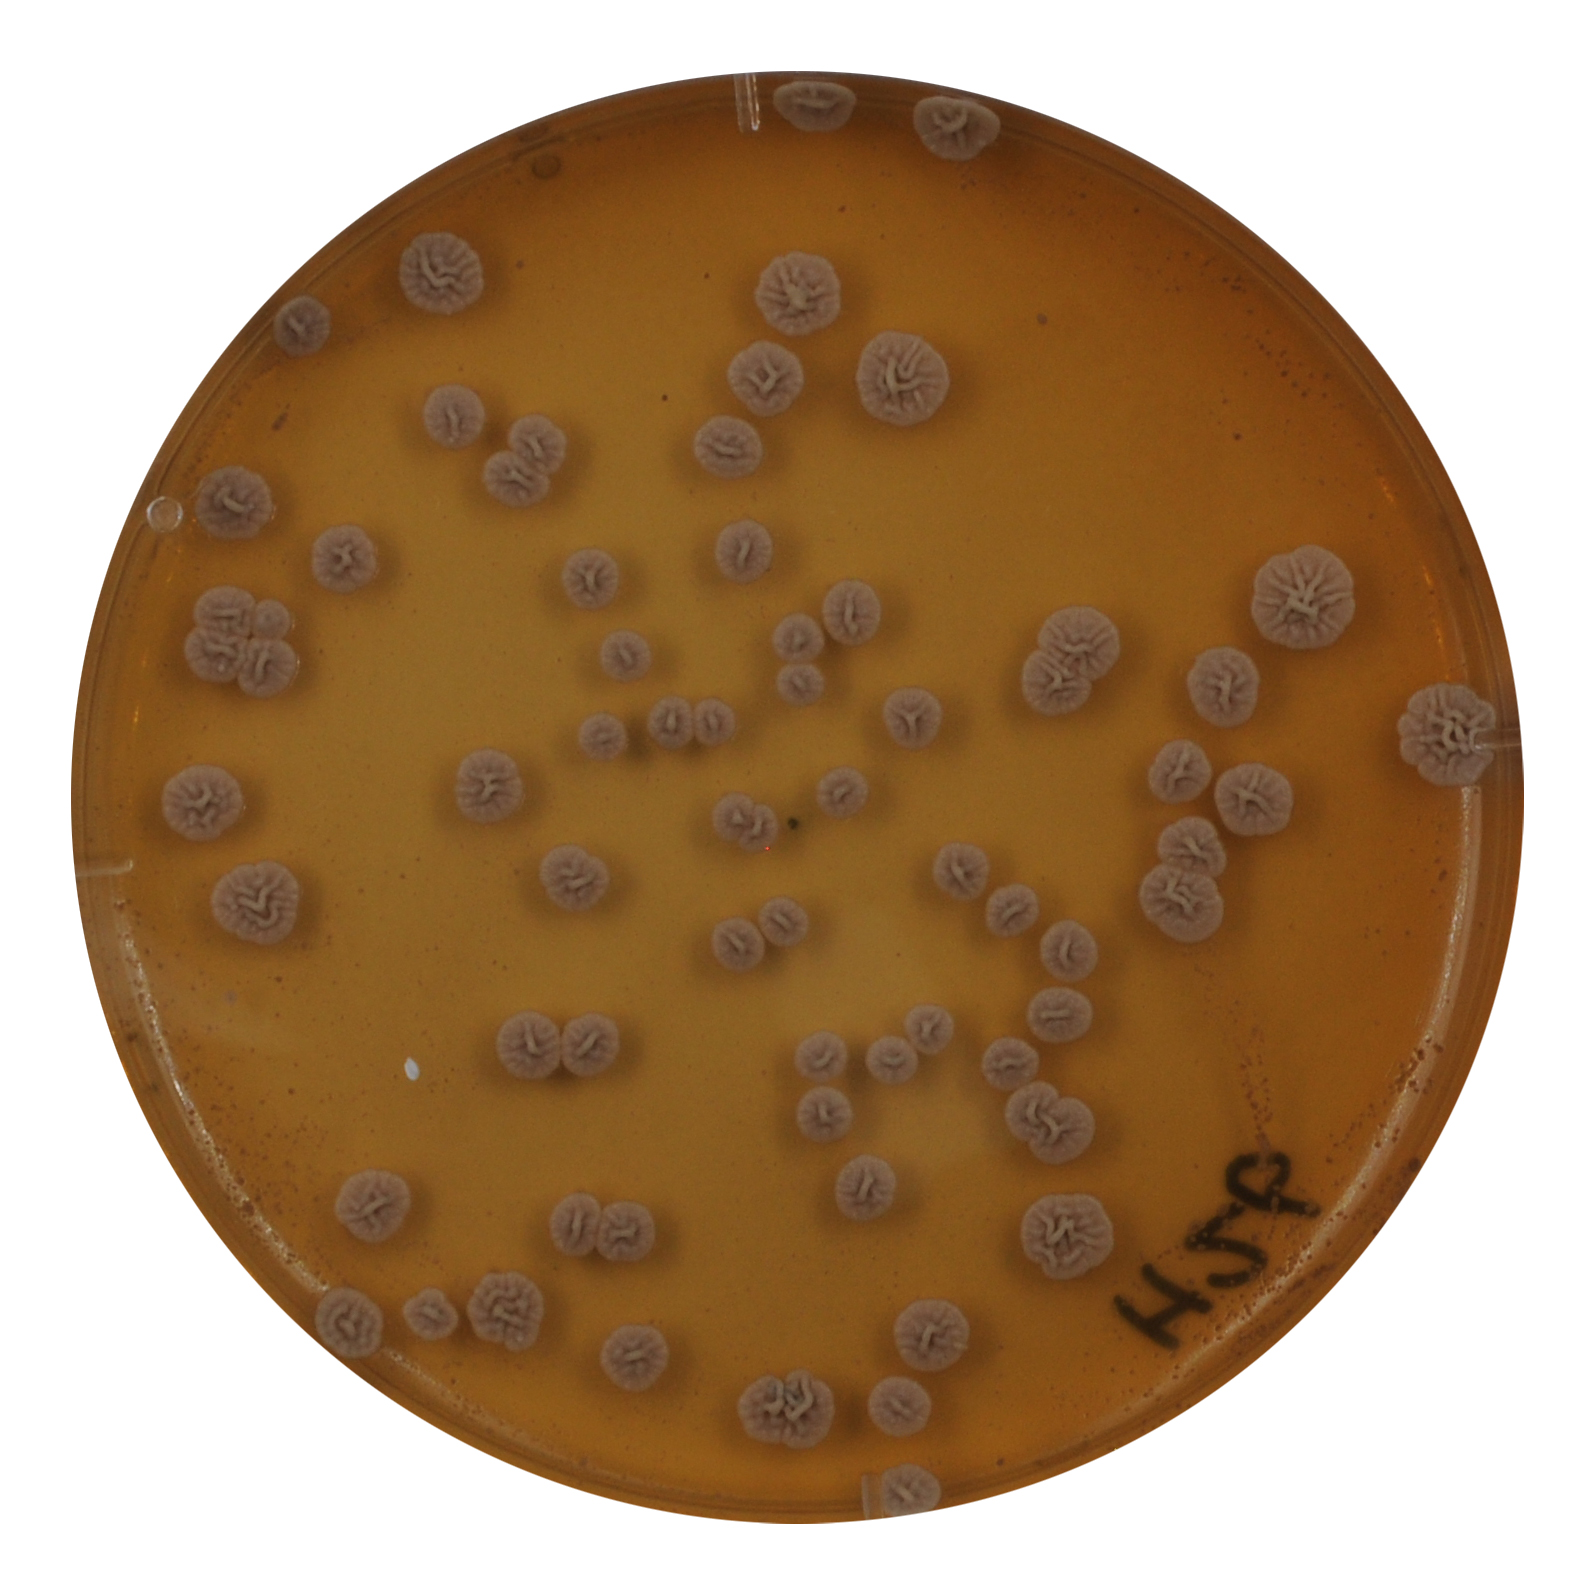

DRAWING ELLIPTICAL ORBIT 01. (2021- )
THE Mill 6, Tsuen Wan HK





Drawing Elliptical Orbit ( when the half moon sets in late summer), size variable, resin, 2022
Color Index
Fusarium oxysporum
Trichoderma harzianum
Aspergillus sp
Fusarium proliferatum
Unknown
Cadophora hiberna (wip)
Talaromyces verruculosus(wip)
Aspergillus niger(wip)
Click mould names for more information
collected moulds from the mill6 building and artifacts

making video
